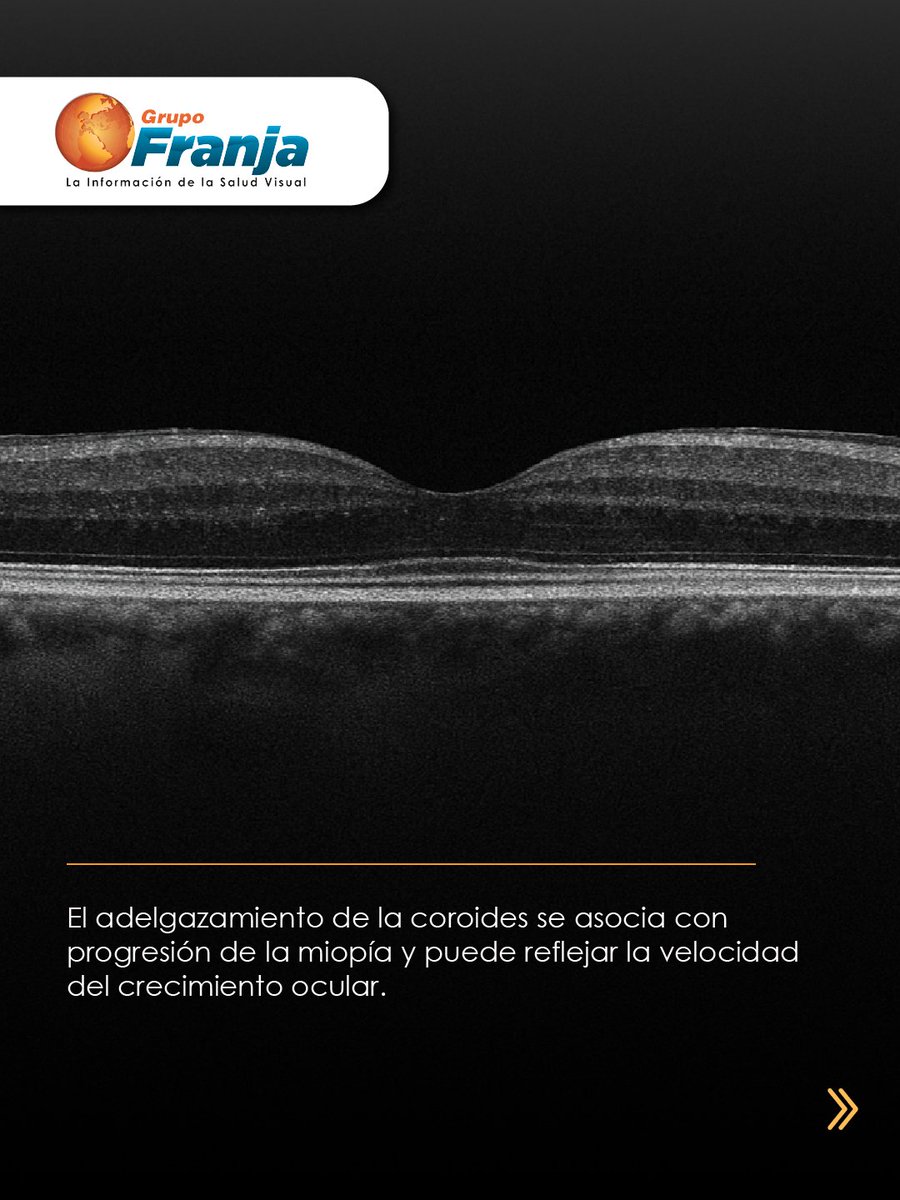
FranjaVisual's tweet image. La coroides podría ser un biomarcador del crecimiento ocular. Estudios recientes muestran que OK y OK + atropina se relacionan con aumentos en su espesor, un hallazgo clave en control de miopía.

👉🏾 f.mtr.cool/pverwixjdt 👈🏾

#NotasFranja #Lentes #SaludVisualConEstilo

Franja Visual
@FranjaVisual
👁️Canal oficial del sector de la Salud Visual. Facebook: @FranjaVisual Instagram:@FranjaVisual YouTube: FranjaTv. 👓🕶️🥽
You might like
#Webinar 👁️ La Dra. María Raziel realizará un recorrido por la embriología del cristalino, su crecimiento, sus capas y su metabolismo. Únete con #iCAPS a las 2 p.m. (Hora Col) 🔴 Transmisión en vivo: YouTube TVFranja 🔁 Retransmisión: 7:00 p.m por linkedin. ¡Te esperamos! ✅

#Webinar Roberto Marzano ofrecerá una actualización del panorama regional, abordando tendencias de crecimiento, realidades y oportunidades del consumidor. Únete con #IACLE a las 11 a.m. (Hora Col) 🔴 Transmisión en vivo: YouTube TVFranja 🔁 Retransmisión: 7:00 p.m por linkedin.

ARIA BLU, de DIVEL Italia, incorpora una estructura con propiedades antirreflejo. 👉🏾 f.mtr.cool/rdwlrcmtxr 👈🏾 #NotasFranja #Lentes #SaludVisualConEstilo #Producto

La calidad visual cambia con el diámetro pupilar. Con aberrometría e IA, los lentes Free Form permiten personalizar la corrección según iluminación y tamaño pupilar. 👉🏾 f.mtr.cool/abtpnojxyh 👈🏾 #NotasFranja #Lentes #SaludVisualConEstilo




🇩🇴 ¿Por qué en Santo Domingo? Porque es el punto más estratégico del Caribe para aprender, conectar y hacer negocios en salud visual. Si quieres crecer, aquí es 📅 21–22 febrero 2026 🔗 franjavisual.co #FranjaRD2026 #SaludVisual #CaribeVisual

🔬✨ Impulsa tu carrera en óptica con Academia Franja Visual. Cursos virtuales para: 👓 Asistente ⚙ Jefe 📊 Gerente 🎓 Formación + Certificación. 👉 Inscríbete: academiafranjavisual.com #AcademiaFranjaVisual #CrecimientoProfesional

Actualiza tu estrategia en el simposio La experiencia del nuevo consumidor, con Hugo A. Sáenz. FRANJA 2026 – Colombia 9 y 10 de julio · Corferias – Bogotá 🔗 franjavisual.co #Franja2026 #Experienciadelnuevoconsumidor #SaludVisual #FranjaVisual #ModaYNegocios

#Webinar El antireflejo sigue siendo uno de los tratamientos más recomendados, pero también uno de los más incomprendidos por los usuarios. Únete hoy con #TC a las 11:00 a.m. (Hora Colombia) 🔴 Transmisión en vivo: YouTube TVFranja 🔁 Retransmisión: 7:00 p.m por linkedin.

Xiaomi Oftalmo del Perú, más de veinte años construyendo un modelo basado en confianza y acompañamiento técnico, convirtiéndose hoy en una referencia para optómetras y oftalmólogos del país. 👉🏾 f.mtr.cool/pnqbjkmjph 👈🏾 #NotasFranja #Lentes #SaludVisualConEstilo #Producto

La coroides podría ser un biomarcador del crecimiento ocular. Estudios recientes muestran que OK y OK + atropina se relacionan con aumentos en su espesor, un hallazgo clave en control de miopía. 👉🏾 f.mtr.cool/pverwixjdt 👈🏾 #NotasFranja #Lentes #SaludVisualConEstilo

#Webinar Martín Gallegos Duarte compartirá cómo su trayectoria profesional y humana ha influido en su forma de comprender y abordar el neuroestrabismo. Únete hoy con #SVH a las 11 a.m. (Hora Col) 🔴 Transmisión en vivo: YouTube TVFranja 🔁 Retransmisión: 7:00 p.m por linkedin.



Vision & Health presentó en el Curso Interamericano de Oftalmología las soluciones que conforman su portafolio para el cuidado integral de la superficie ocular. 👉🏾 f.mtr.cool/jrlnzrybrz 👈🏾 #NotasFranja #Lentes #SaludVisualConEstilo #Producto

¿Puede la inteligencia artificial mejorar la detección temprana del glaucoma? 👉🏾 f.mtr.cool/czypfmybgr 👈🏾 #NotasFranja #Lentes #SaludVisualConEstilo #IA




Durante el Congreso FOCUS 360, NOVAR Technologies y SYMCON anunciaron una alianza global para expandir AI-Coating, un sistema de recubrimientos antirreflejantes impulsado por inteligencia artificial. 👉🏼 f.mtr.cool/cckfdknaxt 👈🏼 #Notas #Lentes #SaludVisualConEstilo #Producto

#Webinar La estimulación visual en la infancia no ocurre solo en sesiones estructuradas: nace y se potencia en la vida cotidiana. Únete con #DC a las 11 a.m. (Hora Col) 🔴 Transmisión en vivo: YouTube TVFranja 🔁 Retransmisión: 7:00 p.m por linkedin.

En FRANJA 2026, César Augusto Erazo lidera el simposio “Lecciones para construir el capital de tu marca”, con estrategias reales para fortalecer el valor de tu marca. 📅 9 y 10 de julio · Bogotá 🔗 franjavisual.co #Franja2026 #MarketingÓptico #Negocios
¿De qué sirve la mejor tecnología si no la estamos usando para conocer realmente a nuestros pacientes? 👉🏼 f.mtr.cool/kyfvdpqydp 👈🏼 #NotasFranja #Lentes #SaludVisualConEstilo




🎓✨ Transforma tu futuro óptico con Academia Franja Visual. Cursos con certificación profesional para impulsar tu carrera desde el primer día. 🚀 Inscríbete ahora y mejora tu camino en el sector óptico. #AcademiaFranjaVisual #FormaciónÓptica
United States Trends
- 1. Thanksgiving 375K posts
- 2. Golesh 2,150 posts
- 3. Fani Willis 12.3K posts
- 4. Trumplican 2,824 posts
- 5. Hong Kong 15.9K posts
- 6. #WipersDayGiveaway N/A
- 7. Khabib 6,644 posts
- 8. Riker N/A
- 9. Stranger Things 159K posts
- 10. Africans 26.1K posts
- 11. Camp Haven 6,763 posts
- 12. NextNRG N/A
- 13. Tom Hardy 1,225 posts
- 14. Ruth 13.7K posts
- 15. #TejRan 4,028 posts
- 16. Elijah Moore N/A
- 17. #Wednesdayvibe 3,606 posts
- 18. Fassbender N/A
- 19. #wednesdaymotivation 6,716 posts
- 20. Idris 7,366 posts
You might like
-
 Funsavi
Funsavi
@funsavi -
 Visión y Óptica
Visión y Óptica
@visionyoptica -
 CGCOO
CGCOO
@Cgcoo_es -
 Visión y Vida
Visión y Vida
@A_VisionYvida -
 optimoda
optimoda
@optimoda -
 OPTOMCongreso
OPTOMCongreso
@OPTOMcongreso -
 expooptica
expooptica
@expooptica -
 AEOPTOMETRISTAS
AEOPTOMETRISTAS
@aeoptometristas -
 Modaengafas.com
Modaengafas.com
@modaengafas -
 Optometristas CyL
Optometristas CyL
@optometristacyl -
 Ópticos-Optometristas de Andalucía
Ópticos-Optometristas de Andalucía
@COOOAndalucia -
 opticas.com.co
opticas.com.co
@opticascomco -
 IPEC CURSOS
IPEC CURSOS
@IpecArgentina -
 COORM
COORM
@coormoficial
Something went wrong.
Something went wrong.































































































































